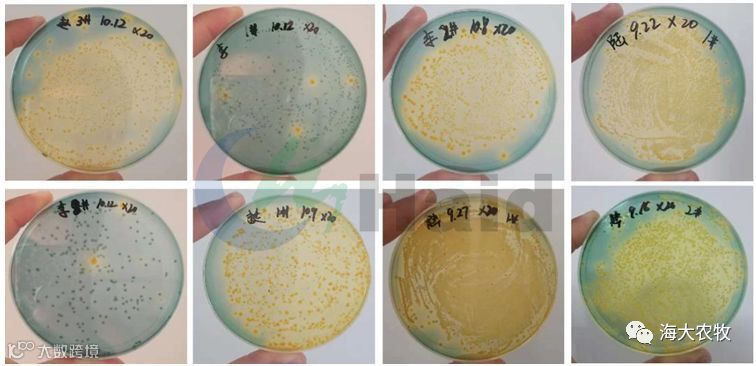
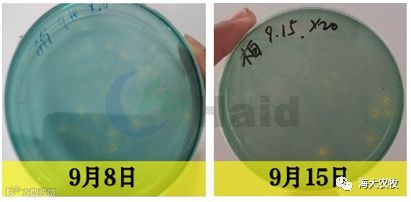
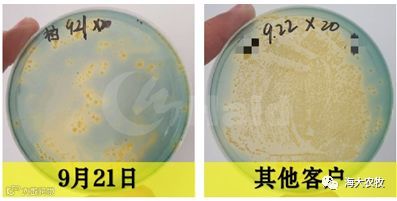
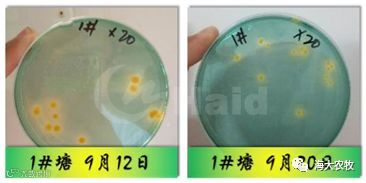

文 | 图 动保事业部 李状状 谢兴
2018年晚造虾陆陆续续已经开始放苗养殖,今年的南美白对虾养殖在早造虾和中造虾养殖阶段成功率非常低,海南高位池养殖成功率不到3成,湛江高位池养殖也是非常低,基本和海南差不多,而由此养殖户今年依然将希望压在了晚造虾上。

海南今年的天气与客户了解到与往年有很大不同,今年进入9月下旬后,天气持续高温,雨水特别少,并且这种高温将一直持续到10月下旬左右,而高温天气情况下池塘水体会变得极其不稳定,极易发生水浓、倒藻、虾子大量褪壳时水体波动大、杂藻(隐藻、裸藻和裸甲藻)和蓝藻占比高等现象,而水体不稳定就引发弧菌超标、水质指标波动大、虾子应激,结果就对虾苗的生长和存活率产生重大影响。

都说苗种好坏是影响养殖效益的最为关键的因素所在,所以选择好苗是我们必不可少的,虾苗放下去之后的管理也是非常关键的。俗话说“养虾先养水,好水养好虾”,水是决定养殖成败的关键因素之一,都说养虾的水要清、爽、嫩,那么这个是需要很好地条件的,而目前外海水和池塘情况却依然延续了从5、6月份一样的“共性问题”——外海水富营养化、矿物质缺乏、杂藻(隐藻、裸藻、裸甲藻)藻种、蓝藻藻种和总碱度偏低等问题,而这些问题往往会导致养殖水体极其不稳定,严重影响了虾苗的成活率以及威胁大虾的健康生长。
通过近期的市场走访和调研,我们收集了海南陵水、东方、儋州、海口四个区域的养殖场池塘水质情况,总共236口高位池,而统计的这些水体中发生倒藻、杂藻多、爆发蓝藻的水体有189口高位池,占比达到了80%以上,而其中发现的矿物质缺乏的达到了203口高位池,占比达到了86%,且其中为出现问题与客户交流也是虾子长时间不褪壳且水开始不稳定但还未出现上述问题。


养殖进入了“金九银十”的季节,这个阶段是大量集中放苗的阶段,都说决胜晚造虾(冬棚),但是这个决胜点也是需要打好前期养殖基础——护好苗、稳好水。可是,天空不作美,海水不给力,导致现阶段养殖前期出现大量危害虾子生长的问题。
1. 在养殖过程中无论是底质、水质,还是虾出现问题,往往是由于水中藻相变坏引起的。水中藻相变差会直接引起水体波动变大、水中死藻增多、倒藻、水变浓、泡沫多、死藻分解产生悬浮颗粒和沉淀底质等诸多问题,统计了几个客户的几口出现问题的塘口和几口水质非常稳定的塘口藻相,发现区别很大。

由于水体的隐藻、裸藻、裸甲藻、蓝藻等有害藻可以大量吸收水中营养盐和矿物质元素并且繁殖快速、白天占据水体上层空间导致硅藻、绿藻等有益藻缺乏营养盐和生长空间产生老化严重、活力差、繁殖力弱等现象,使得水体变得更加不稳定、危害时刻存在。

2. 水体藻类坏死后沉淀到池底后会导致底部变脏,而藻类死亡之后导致种类变少,进而引起产氧能力下降,底部缺氧,沉淀死藻会在缺氧情况下产生弧菌、氨氮、亚硝酸盐等有毒有害物质,而对跟踪的池塘进行弧菌结果显示统计水不稳塘口弧菌几乎全部超标,已严重威胁虾子正常生长。

3. 藻类死亡之后分解会产生藻毒素,对虾子影响最大的就是引起藻中毒,首先引起的就是虾子肝胰腺中毒,而肝胰腺是虾子分解消化酶、分解酶等主要酶类的器官,当中毒之后就会严重影响酶类分解能力,那么运输到肠道的就会减少,进而加剧肠道的负荷,引起虾子肠道炎症和慢料现象。


对于上述问题我们遇到的就是要去尽快去解决,但是养虾重在的是“预防为主,防治结合”,对于上述问题我们也是要问题解决方案作为后续的预防方案,前面一段时间讲过矿物质元素对菌藻虾的重要性,那么进入十一月份后,随着温度的降低,总菌也会因温度降低而减少,那么我们就都得通过补来维持池塘菌藻虾生存所需量、维持菌藻平衡及防控弧菌爆发。
1. 水不稳问题分析
通过前面的大数据分析和总结,我们知道水中缺乏矿物质元素会导致水体菌藻虾极其不稳定,加之水源中含有杂藻、蓝藻藻种和富营养化,进而导致出现各种问题,因此处理思路是遮光控杂藻、补菌控弧菌和补矿稳水。

2. 海大稳水综合处理及预防方案
对于养虾来说,生态系统的稳定性是虾子生长顺利的保护伞,因此我们很少建议客户通过杀菌杀藻的措施来将生态系统完全打破然后重建,海大预防和处理方案均是以减少虾子二次危害为主:
♣ 除控杂藻、蓝藻:黑精灵(10斤/亩)或水精灵(1瓶/2~3亩)
♣ 补菌控藻控弧菌:泡菌(虾多宝1包+益菌素5斤+益菌多1瓶+150斤水,密封发酵48小时)10斤/亩
♣ 补矿稳水又壮虾:钙镁佳(1包2亩)+钙速补(1瓶2亩)
3. 优质客户稳水案例分享
《稳水案例分享(一)
背景:海南东方英显柏老板3亩高位池,9月8日放苗70万。因为近期天气比较闷热,池塘容易发生变化,客户为了稳定水质,放苗后根据天气情况使用黑精灵(10斤/亩)进行遮光防控藻类繁殖过快,每隔2~3天使用泡菌(虾多宝发酵液,10斤/亩)进行控制弧菌生长和控藻,同时每隔4天池塘补充1包钙镁佳和钙速补(1瓶2亩)促进菌藻生长和延长菌藻生存时间。
使用效果:
1. 水体非常稳定,水质非常清爽,水中颗粒物质非常少,主要以茶褐色为主。

2. 水中各项指标保持稳定,水中矿物质保持在较高水平。


3. 水中弧菌保持在较低水平,没有绿菌,对虾子危害非常小。

稳水案例分享(二)
背景:海南东方旦场园易老板2口均是3亩高位池,9月12日均放苗30万,因客户刚从儋州过来养殖,对附近海域水源情况不了解,帮其检测水质和告知海域水源富营养化后,客户也是采取我司方案根据天气情况使用黑精灵(10斤/亩)进行遮光防控藻类繁殖过快,每隔2~3天使用泡菌(虾多宝发酵液,10斤/亩)进行控制弧菌生长和控藻以及每隔3~5天每个塘补充1包钙镁佳和钙速补(1瓶2亩)稳定水质和促进菌藻平衡生长。
使用效果
1、水色保持茶褐色,水质非常嫩爽,水中悬浮颗粒非常少,藻相主要以硅藻和绿藻为主,种类丰富,稳定性好。

2、水中各项指标非常稳定,8~9格盐度下水中矿物质元素满足菌藻虾生长需求,水体长久保持稳定。

3、水中弧菌非常少,定期检测均保持在较低水平,无绿菌,对虾影响很小。

稳水案例分享(三)
背景:海南东方四更赵老板6亩左右高位池,9月1日放苗130万左右,自从放苗以后客户为了稳定水质提高苗种存活率,不定期使用黑精灵(5斤/亩)遮光防控杂藻和水浓,定期补菌(每天2餐使用虾多宝(按饲料量的20%)和饲料密封发酵2小时然后投喂)控弧菌和每隔3~5天使用钙镁佳(1包3亩)延长菌藻存活时间和促进菌藻平衡。
使用效果:
1. 水质清爽,泡沫很少,悬浮颗粒很少,透明度维持在20~35公分,水色以茶褐色为主。


2. 水中各项指标稳定,水中矿物质元素平稳,水体长久稳定。

3. 水中弧菌非常少,对虾影响危害很少,长期补菌效果强。


养虾重在预防,只有及时发现池塘的变化才能管理好水质,而等到出现问题再去治疗总是会对虾子后续生长产生影响,因此会出现虾子慢料、生长慢等现象;严重者会出现偷死、排塘现象,由此预防最为关键。
1. 遮光控藻,防控水浓
隐藻、蓝藻、裸藻、裸甲藻等有害藻具有趋光性,通过遮光手段防控有害藻滋生,同时也可以防控水变浓,有蓝藻时建议使用黑精灵。

2. 以菌抑菌,严控弧菌
弧菌在养殖过程中一直存在着,如果彻底杀掉那是不可能的,并且经常杀菌对养殖生态系统的破坏非常大,虾子也生存艰难,那么我们以菌抑菌来防控弧菌是最有力的措施,泡菌(虾多宝1包+益菌素5斤+益菌多1瓶+水150斤,密封发酵48小时)也得到了客户的认可。

3. 补矿稳水,菌藻平衡
水中菌藻虾生长犹如人类生长也需要各种营养元素,而这些营养元素就是各种营养盐和矿物质元素如钙、镁、钾、磷等元素,而藻类生长和光合作用主要利用镁元素,虾生长主要利用钙元素,因此矿足水才能稳,虾才能壮。

“养虾先养水,水好虾才好”好水才能保证虾苗有一个高的成活率,养虾水要稳,稳中方能取胜。高温天水易变是一个共性问题,尤其是藻不稳、有益菌存活时间不长、有害菌(如弧菌)滋生,因此稳水很关键。高温天黑精灵配合泡菌和补充钙镁佳矿物质元素可以有效利用黑精灵的遮光效果防控藻生长过旺水变浓以及杂藻(隐藻、裸藻、蓝藻等有害藻)生长,泡菌(虾多宝+益菌素+益菌多)所扩培的大量乳酸菌、酵母菌压制弧菌生长和分解水中有机物提供营养盐,而钙镁佳提高的矿物质元素可以促进菌藻平衡生长和延长存活时间,促进水体稳定。

湛江海大 精彩文章







